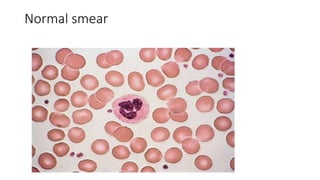
Normal smear
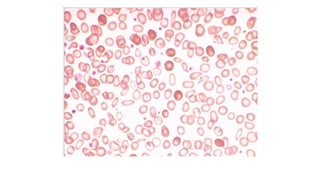

1. The document discusses hematologic disorders including hematopoiesis, anemia, polycythemia, and hematologic malignancy.
2. It provides details on the pathophysiology of hematopoiesis, the definition and classification of anemia, the general approach to evaluating anemic patients, and discussions of common anemia types and their treatments.
3. Key anemia types covered include iron deficiency anemia, megaloblastic anemia due to vitamin B12 and folate deficiencies, and the morphological features seen in peripheral blood and bone marrow in these conditions.